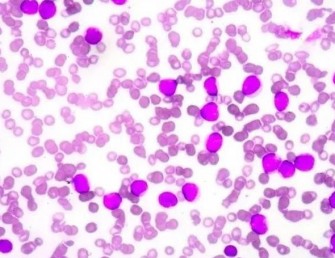
L&rsquo;An&eacute;mie de Fanconi

L’Anémie de Fanconi
L’anémie de Fanconi (AF) est une maladie génétique rare qui affecte principalement la moelle osseuse, entraînant une production réduite de cellules sanguines. Cette maladie est associée à diverses anomalies physiques et à un risque accru de cancer, en particulier de leucémies et de carcinomes épidermoïdes.
Faisant partie des syndromes héréditaires d’insuffisance médullaire, dysfonctionnements affectant la production de cellules souches du sang dans la moelle osseuse. Elle conduit à des anomalies congénitales et à une prédisposition à certains cancers. Elle touche les deux sexes et son diagnostic est souvent fait tardivement, au stade de l’apparition de l’insuffisance médullaire. L’évolution hématologique se fait vers une aplasie médullaire sévère ou une leucémie.
Symptômes et caractéristiques
La maladie de Fanconi est caractérisée par un ensemble de malformations congénitales variables, une insuffisance de la moelle osseuse d’apparition retardée et un risque élevé de leucémie aiguë et de cancers.
Son diagnostic peut être difficile et est rarement fait à un stade précoce. Il est souvent posé en raison des malformations congénitales ou au stade d’apparition de l’insuffisance de la moelle osseuse.
Il existe une très grande hétérogénéité des signes cliniques qui peuvent être très variables d’un individu à un autre et ceci est également vrai au sein d’une même fratrie.
Les principaux signes cliniques
Les premiers signes cliniques sont les malformations congénitales très hétérogènes.
Elles peuvent concerner notamment :
- le squelette : anomalies des pouces ou des radius, microcéphalie (petit périmètre crânien, aspect particulier du visage), petite taille
- les reins et l’appareil urogénital
- le tube digestif (atrésie de l’œsophage, etc.)
- l’appareil auditif
- les yeux
- la peau : tâches café au lait
- les glandes endocrines
- le système nerveux central
- le cœur et les poumons
La petite taille est une des caractéristiques les plus fréquentes : elle débute pendant la vie utérine et les enfants naissent le plus souvent petits. Dans la grande majorité des cas, mais pas pour tous, on observe un retard de croissance modéré mais il peut être plus marqué chez certains patients ou inversement peu marqué. Cette petite taille est souvent due à des déficits hormonaux mais pas toujours.
Il n’y a pas, le plus souvent, de retard du développement psychomoteur ou intellectuel.